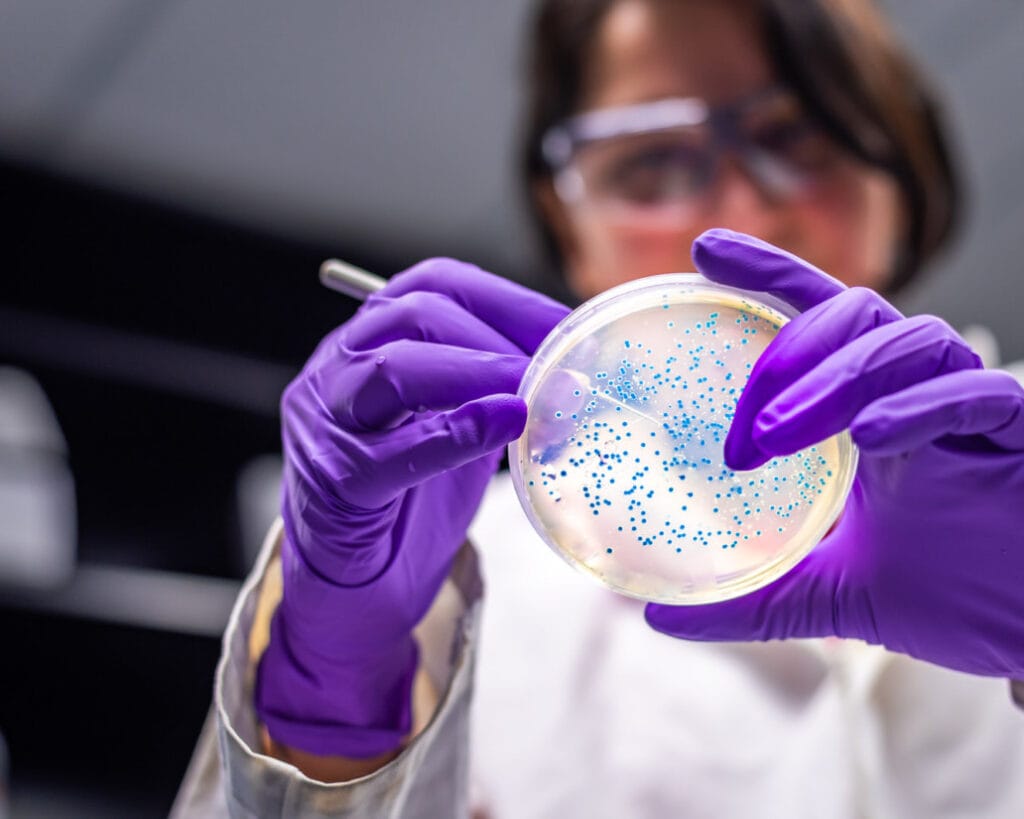

¿Qué es la cistitis?
La cistitis o infección de orina constituye una de las enfermedades infecciosas más frecuentes. La mayoría ocurre en mujeres sin enfermedades de base y sin anomalías funcionales o estructurales del tracto urinario. Es más común en las mujeres, se estima que un 60% de las mujeres presentan una infección en el tracto urinario a lo largo de su vida y de un 30 a 40% padecen recurrencia.
Alrededor del 25 al 50% de todas las mujeres jóvenes sanas que sufren su primera infección de orina o cistitis, desarrollarán una segunda en un período de 6 meses.
Es más común en las mujeres, se estima que un 60% de las mujeres presentan una infección en el tracto urinario a lo largo de su vida y de un 30 a 40% padecen recurrencia.

Según haya presencia o ausencia de anormalidades funcionales o anatómicas del tracto urinario y patrón de resistencia antimicrobiana del uropatógeno, distinguimos las siguientes infecciones urinarias (IU):
No complicada
Ocurren en el tracto urinario (TU) normal de los individuos inmunocompetentes, por lo general mujeres jóvenes sanas no embarazadas, sin defectos estructurales del TU, ni trastornos de la función renal y con síntomas que se limitan a la vejiga, como escozor miccional, urgencia miccional, polaquiuria, dolor suprapúbico o tenesmo. Ausencia de fiebre o dolor lumbar sugestivos de pielonefritis.
Recurrente (IUR)
Ocurren en el tracto urinario (TU) normal de los individuos inmunocompetentes, por lo general mujeres jóvenes sanas no embarazadas, sin defectos estructurales del TU, ni trastornos de la función renal y con síntomas que se limitan a la vejiga, como escozor miccional, urgencia miccional, polaquiuria, dolor suprapúbico o tenesmo. Ausencia de fiebre o dolor lumbar sugestivos de pielonefritis.
Complicada
Ocurren en el tracto urinario (TU) normal de los individuos inmunocompetentes, por lo general mujeres jóvenes sanas no embarazadas, sin defectos estructurales del TU, ni trastornos de la función renal y con síntomas que se limitan a la vejiga, como escozor miccional, urgencia miccional, polaquiuria, dolor suprapúbico o tenesmo. Ausencia de fiebre o dolor lumbar sugestivos de pielonefritis.
¿Cómo se produce la cistitis?
Para que se produzca una infección de orina o cistitis, primero las bacterias deben entrar en la uretra (que es estéril) y ascender hasta la vejiga. Posteriormente se produce una respuesta inflamatoria en la mucosa. Aunque la infección se concentra principalmente en la vejiga, puede extenderse y alcanzar los riñones.
Habitualmente las bacterias provienen de las heces, predominando la Escherichia coli, causante de más del 80% de las infecciones no complicadas en mujeres sexualmente activas.
Las bacterias más comunes causantes de las Infecciones del Tracto Urinario son la E. coli, Proteus mirabilis; Klebsiella pneumoniae; Staphylococcus saprophyticus; Enterococcus faecalis y Streptococcus agalactiae.
¿Cuánto dura la cistitis?
No existe un tiempo determinado para la duración de una cistitis o infección de orina, depende de cada caso y de cada persona. Por ejemplo, influye el tiempo que se tarde en visitar a un/a profesional para que determine el problema y el mejor tratamiento a seguir. Si se ignoran los síntomas durante un periodo largo de tiempo, pueden ir empeorando y agravando la infección.
En la mayoría de las ocasiones, el cuerpo es capaz de deshacerse de estas bacterias a través de la orina, sin embargo, las bacterias pueden adherirse a la pared de la uretra o vejiga o también multiplicarse de manera tan rápida, de forma que algunas bacterias consigan permanecer en la vejiga.
Las mujeres son más propensas a contraer infecciones del tracto urinario con mayor frecuencia que los hombres. Esto se debe a que la uretra es más corta y está más próxima al ano, por lo que el traslado de bacterias fecales es más fácil.
Las infecciones de orina en las mujeres también se ven favorecidas por las relaciones sexuales, pues el acceso a la uretra de las bacterias que se encuentran en el exterior puede verse favorecido por los movimientos sexuales.

Síntomas de la cistitis
Lo normal es que, en el cuadro clínico de la cistitis, no se produzca fiebre, aunque si se da el caso, puede ser indicación de que se está produciendo otro tipo de infección más grave, en la que se está viendo afectado algún órgano.
El órgano afectado puede ser el riñón, dando lugar a lo que se conoce como pielonefritis aguda. Una enfermedad caracterizada por fiebre, escalofríos, malestar general, dolor lumbar acompañado de bacteriuria significativa.
Tipos de cistitis
Cistitis infecciosa bacteriana
Este tipo de infección de las vías urinarias suele ocurrir cuando algunas de las bacterias que se encuentran en el exterior, consiguen acceder al interior de las vías urinarias a través de la uretra, donde empiezan a crecer.
La bacteria que, normalmente, es la causante de la mayoría de las cistitis bacterianas que se producen es la Escherichia coli (E. coli). Este tipo de infección en las mujeres puede verse favorecida por las relaciones sexuales, dando lugar a lo que se conoce como cistitis postcoital.
En general, las mujeres siempre están expuestas a sufrir infecciones de orina o cistitis, aunque sean más leves, pues en la zona genital habitan numerosas bacterias que pueden provocar estas infecciones asiduamente. De hecho, uno de los principales problemas de las cistitis bacterianas son su alto nivel de recurrencias, pero ¿por qué ocurre?
Cistitis Postcoital
Los movimientos durante el coito facilitan el acceso de las bacterias fecales a la vagina y/o vejiga por su proximidad al recto. Esto no quiere decir que cada vez que se tiene una relación sexual vaya a producirse una infección de orina, solo que es más probable que pase.
La lubricación y los anticonceptivos también pueden ser precursores de la cistitis postcoital. Cuando la lubricación es insuficiente, la vagina es propensa a irritarse, creándose heridas que fomentan el desarrollo de infección
Cistitis infecciosa bacteriana
Aunque lo común es que la cistitis sea infecciosa (producida por una bacteria) puede darse el caso de que sean otros los motivos por los cuales se inflame la vejiga.
Algunos de estos motivos son:
Cistitis intersticial
La causa de este tipo de cistitis no está muy clara, aunque se sabe que mayormente se presenta en mujeres. Es una inflamación crónica de la vejiga que, al ser difícil de diagnosticar y de establecer una causa, es difícil de encontrar un tratamiento efectivo. Incluye los síntomas y molestias de una cistitis aguda, pero de forma crónica.
Cistitis derivada del consumo de medicamentos
Existen algunos medicamentos (por ejemplo, relacionados con la quimioterapia) que pueden producir, como efecto secundario, una inflamación y daño en el aparato urinario al pasar sus restos por los conductos para ser expulsados en la orina.
Cistitis por radiación
Al igual que en el caso anterior, el tratamiento por radiación puede producir inflamación y daño en la vejiga.
Cistitis por cuerpos extraños
El uso de catéteres, sobre todo si es durante un largo periodo de tiempo, puede provocar infección e inflamación en aparato urinario.
Cistitis química
Este tipo de cistitis viene producida por el uso de ciertos productos que contienen sustancias a las que algunas personas pueden ser más hipersensibles, se produce una reacción y se genera la inflamación de la vejiga. Un ejemplo de estos productos pueden ser los geles espermicidas.
Cistitis derivada de otras afecciones
Puede darse el caso en el que la cistitis aparece como una complicación de otros trastornos, como pueden ser la diabetes, los cálculos renales, el agrandamiento de la próstata o las lesiones de la médula espinal.
¿Por qué vuelve la cistitis?

Se considera una cistitis recurrente o de repetición cuando se tienen 3 o más en un tiempo inferior a un año o 2 infecciones en los últimos 6 meses. La recurrencia puede deberse a una recidiva o una reinfección.
Cuando se produce una reinfección, se trata de infecciones diferentes, es decir una ya se ha resuelto cuando se produce la siguiente con una bacteria diferente a la inicial.
Las reinfecciones suponen aproximadamente un 80% de las infecciones recurrentes y ocurren después de 2 semanas de completar el tratamiento. Puede ser por cepas distintas o la misma cepa de la infección original a causa de un reservorio en el tracto gastrointestinal o en las propias células uroepiteliales.
Sin embargo, en las recidivas se trata de la misma infección que vuelve a activarse, es decir está siendo originada por la misma bacteria que provocó la inicial, que no hemos conseguido eliminar definitivamente.
Las recidivas son un 20% de las recurrencias y aparecen a las dos semanas de la aparente curación de la cistitis (persistencia de la cepa original en el foco de infección), bien por anomalía genitourinaria o por acantonamiento en un lugar inaccesible al antibiótico. Lo normal en una recidiva es que se produzca cuando la bacteria que produce la infección es la E. coli, que suele ser la causa de entre el 75 y 95% de los episodios de cistitis aguda no complicada. La bacteria E. coli está compuesta por unas fimbrias (estructuras adherentes) que se adhieren a unos receptores que se encuentran en las células epiteliales del huésped. Estas fimbrias son las que provocan las recidivas, pues cuando se anclan a la pared celular son muy difíciles de soltar, además se pueden camuflar entre los pliegues de las paredes, de forma que el tratamiento antibiótico no consigue actuar eficientemente contra ellas y por eso reaparecen al poco tiempo.

Tratamiento cistitis
Si se considera conveniente, también se podrá realizar un análisis de orina para detectar bacterias y/o sangre en la orina o una cistoscopia, que es una prueba en la que se introduce una cámara por la uretra hacia la vejiga para detectar posibles anomalías. En algunos casos, también pueden realizarse pruebas de diagnóstico por imágenes como radiografías o ecografías. Cada vez más, se ha normalizado el tratamiento antibiótico en periodos cortos de tiempo, para evitar la resistencia bacteriana. Además, como apoyo al antibiótico, cada vez es más común la recomendación de algún probiótico que ayude a mejorar los síntomas, a fomentar y mejorar el efecto del antibiótico y que además sirva como preventivo para evitar las recurrencias.
Cada vez es más común la recomendación de algún tratamiento que ayude a mejorar los síntomas y mejore el efecto del antibiótico evitando recurrencias, como Urocran Forte


Lo más común, en el caso de cistitis causadas por bacterias, es el empleo de antibióticos. Antes de que se inicie el tratamiento con antibióticos, es importante que el/la profesional determine si la persona tiene alguna enfermedad o trastorno que pueda empeorar la infección o dificultar el tratamiento. Otro tratamiento farmacológico que puede emplearse ante una cistitis es la vacuna, realizadas a partir de extractos bacterianos de cepas uropatógenas.
También existen alternativas no farmacológicos que cada vez son más empleados, entre los que podemos encontrar:
D-Manosa
es un azúcar simple, que puede actuar en el tracto urinario se une a la E- coli y desactiva las capacidades adhesivas e invasivas de esta bacteria, debido a la similitud estructural con los receptores de los patógenos.
Vitamina C
acidifica la orina y mejora la flora intestinal, que tiene una incidencia indirecta en la ITU al mejorar el funcionamiento del SI
Estrógenos tópicos
por vía vaginal aumentan la concentración vaginal de lactobacilos, disminuyen el pH vaginal y reducen las infecciones urinarias recurrentes, especialmente en pacientes posmenopáusicas.
Lactobacillus
los probióticos son microorganismos vivos que cuando se administran en cantidades adecuadas confieren un beneficio a la salud del hospedador. (FAO/WHO 2002) Los Lactobacillus es un género de bacterias que se encuentran naturalmente en la vagina y uretra de la mujer sana. Un bajo recuento de Lactobacillus está directamente relacionado con un elevado número de E. coli en vagina aumentando la frecuencia de las infecciones urinarias. Los Lactobacilos producen agentes antimicrobianos, como el ácido láctico, peróxido de hidrógeno (H2O2) y bacteriocinas, y bloquean sitios potenciales de unión del uropatógeno.
Arándanos rojos
el extracto seco de arándano rojo americano (Vacciunium macrocarpon) es capaz de establecer un barrera físico-mecánica natural contra la adherencia de E. coli a la superficie de las células epiteliales de la vejiga y el tracto urinario.
Xiloglucano
polisacárido presente en el árbol Tamarindus indica. Actúa en la luz del intestino, evita la adhesión, el crecimiento bacteriano y la migración a otros órganos.